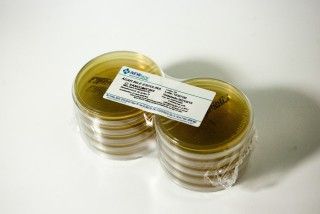

ÁGAR BILE ESCULINA COM VANCOMICINA pcte com 10 placas 90x15mm
Fabricante:Newprov

Categorias:Microbiologia
Meio de cultura para isolamento de estreptococos do grupo D resistentes à vancomicina
Pacote com 10 placas
Validade: 120 dias
Conservar entre 2 a 8º C
Código: PA06
Para saber mais, clique abaixo em quero mais informações.
Resumo
Meio de cultura para isolamento de estreptococos do grupo D resistentes à vancomicina
Pacote com 10 placas
Validade: 120 dias
Conservar entre 2 a 8º C
Código: PA06
Para saber mais, clique abaixo em quero mais informações.
COMPARADOR
Adicione mais produtos
para comparar